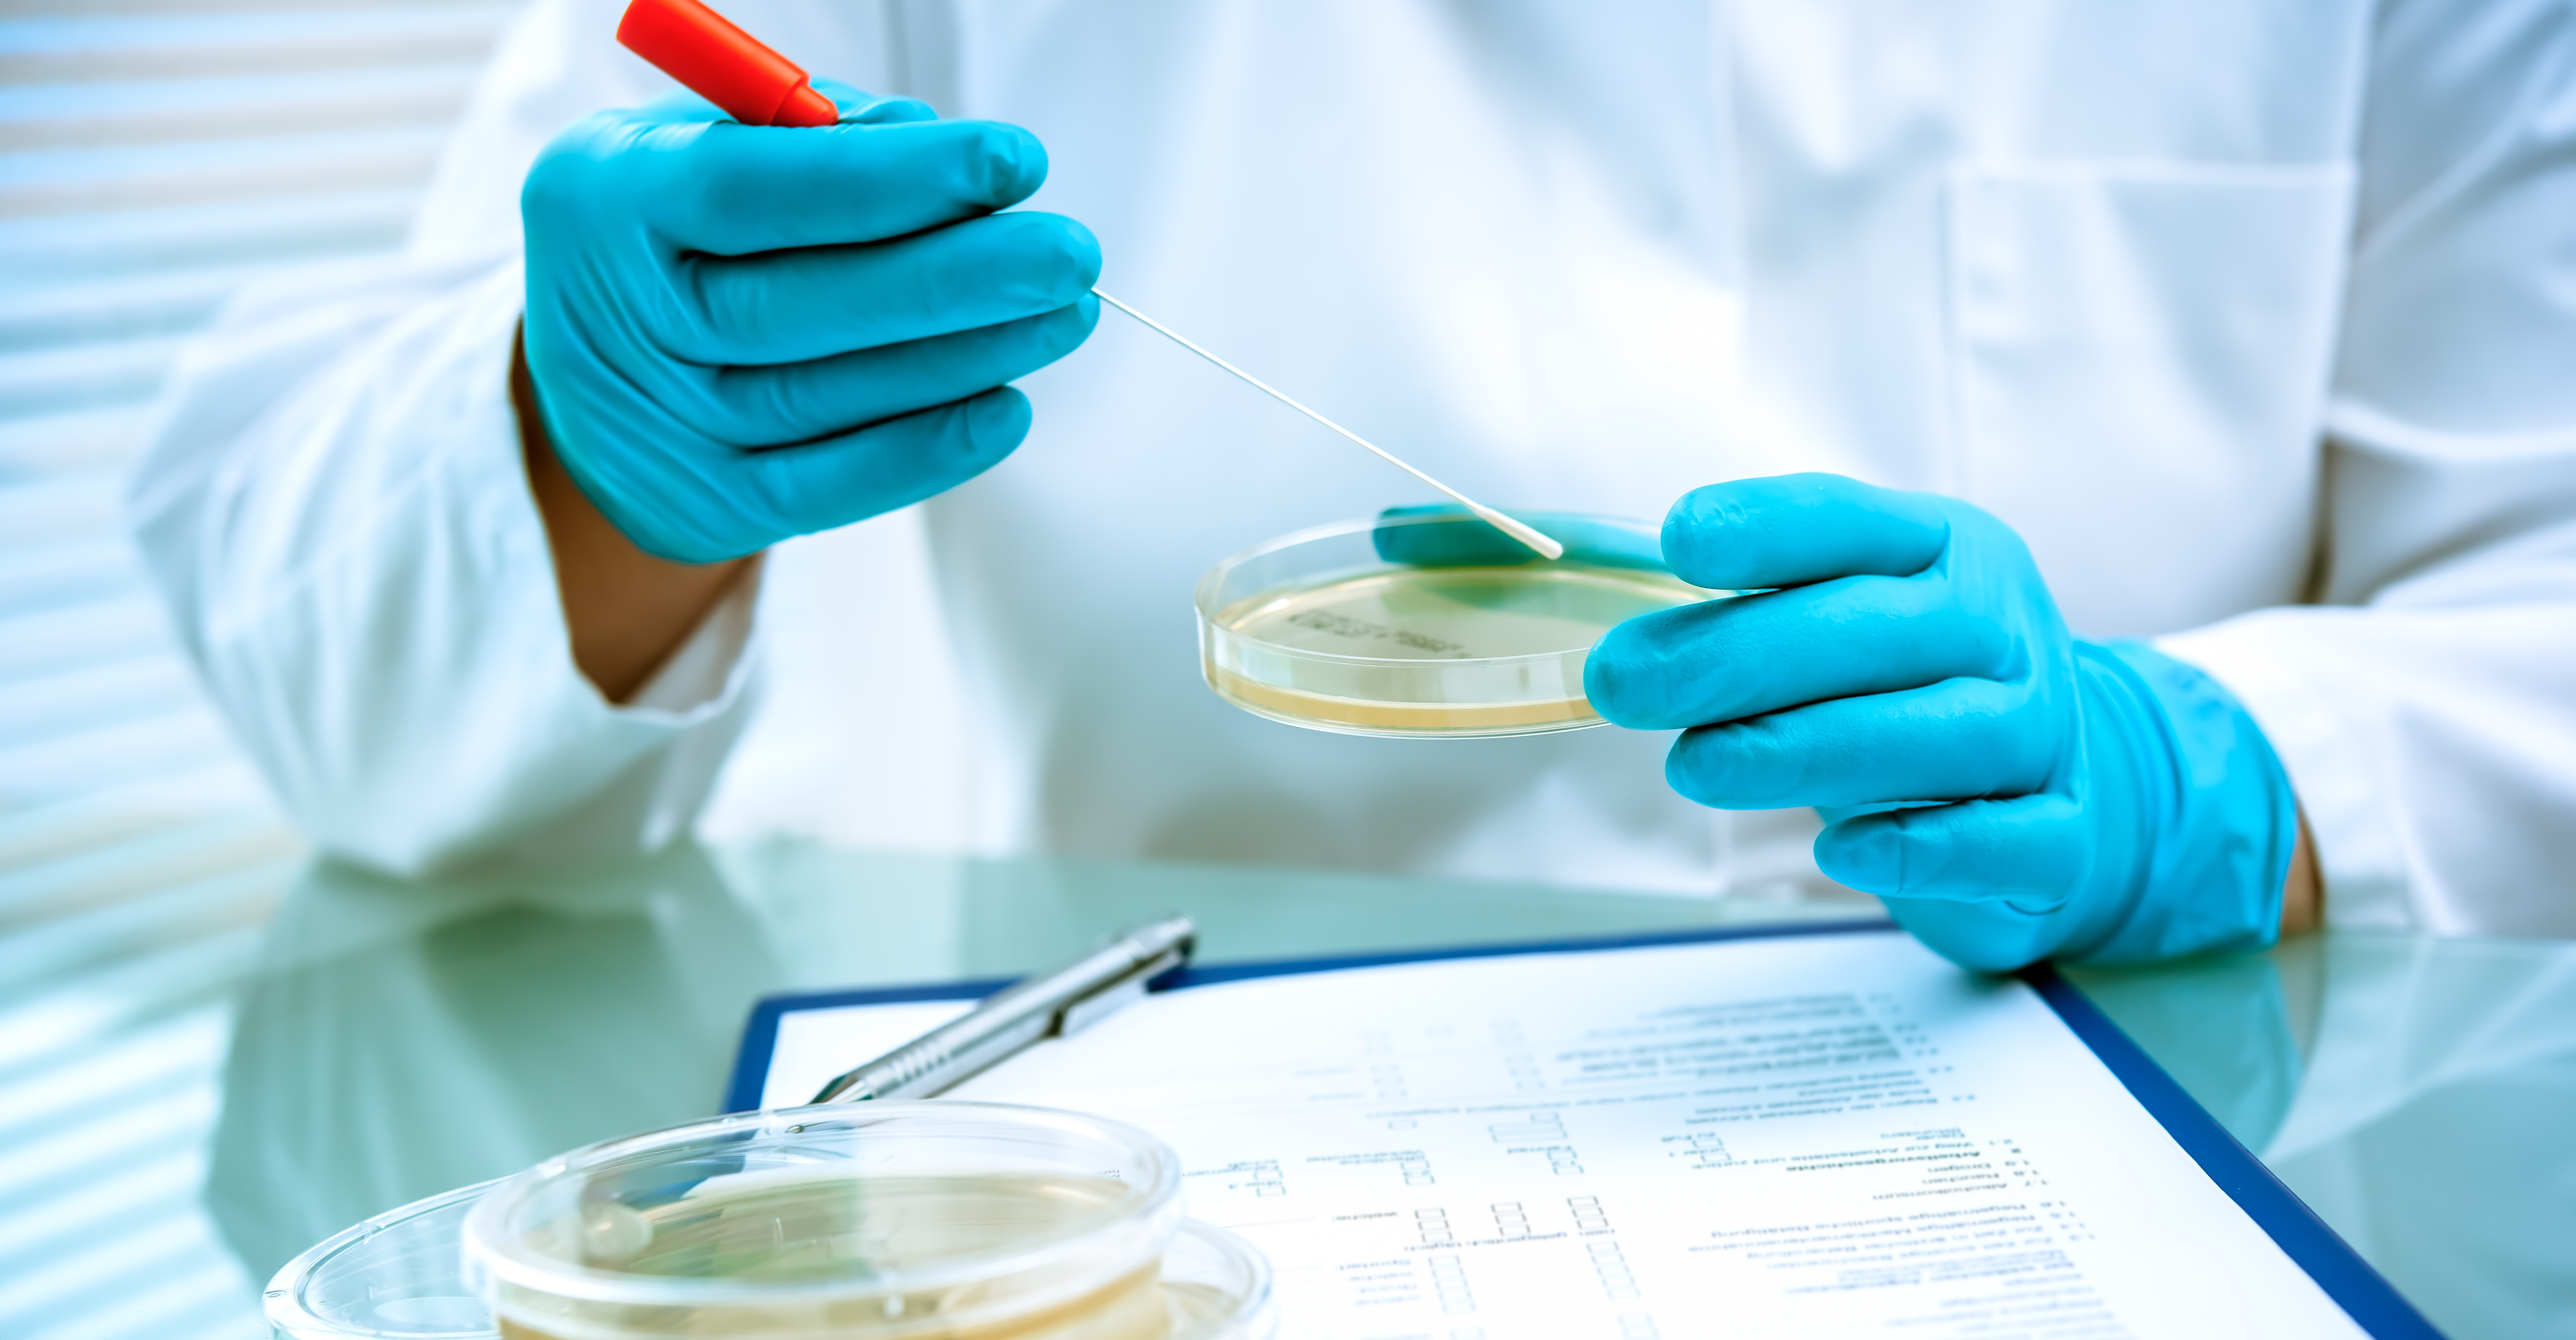

-
Phone
+1 876-279-9158
+1 876-618-4536 - E-mail citydiagnosticmedicallab@gmail.com
- Opening Hours Mon-Sat : 8am - 5pm
CDML's microbiology services stand as a cornerstone in the accurate identification and characterization of microorganisms. Utilizing cutting-edge technology and a proficient team, we conduct a diverse array of tests to detect bacteria, viruses, fungi, and parasites. From culturing and sensitivity testing to pathogen identification, our precise analyses aid in diagnosing infectious diseases and guiding effective treatment strategies. Count on CDML for comprehensive microbiology testing, contributing significantly to the management and prevention of infectious illnesses, ensuring the well-being of patients and communities.